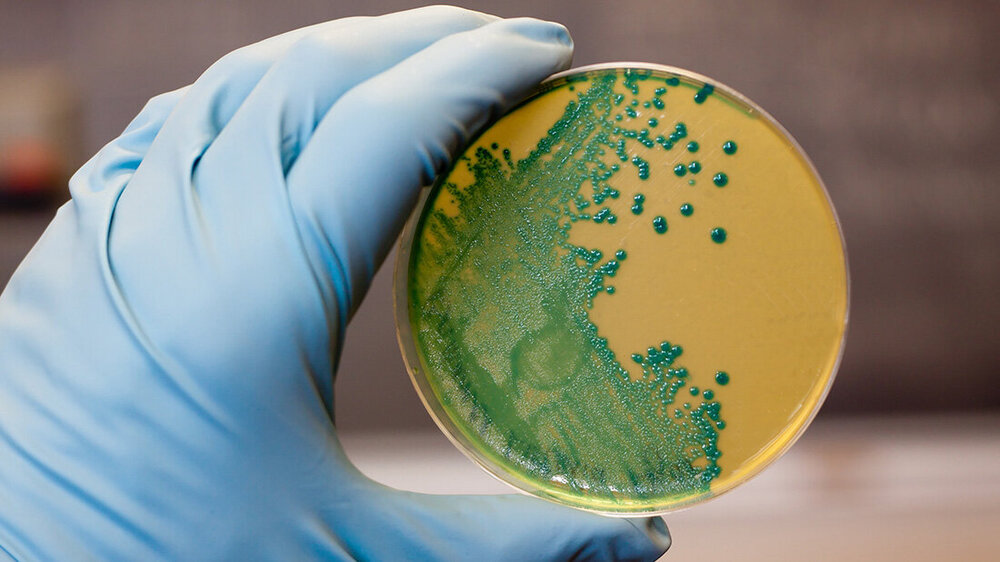
Listerien_ggw.jpg Hand mit Schutzhandschuh hält eine Petrischale, in der Bakterien ausgestrichen sind.

Lebensmittelrückruf: Listerien häufiger Auslöser
Um das Online-Angebot der MT im Dialog uneingeschränkt nutzen zu können, müssen Sie sich einmalig mit Ihrer DVTA-Mitglieds- oder MT im Dialog-Abonnentennummer registrieren.
Möchten Sie eine Anzeige in der MT im Dialog schalten?
MT im Dialog ist das offizielle Organ des Dachverbandes für Technologen/-innen und Analytiker/-innen in der Medizin Deutschland e.V. (DVTA). Als führende Fachzeitschrift unterstützen wir Medizinische Technologinnen und Technologen und Lehrkräfte in allen Fragen ihres Berufsfeldes.
In Fachbeiträgen aus Theorie und Praxis werden moderne Untersuchungsmethoden, Neuentwicklungen aus der Medizintechnik und Diagnostik anschaulich vorgestellt. Zudem können unsere Mitglieder regelmäßig Beiträge zu Ausbildung, Berufspolitik, Arbeits- und Berufsrecht der Medizinischen Technologinnen und Technologen lesen. Mit Interviews, Porträts, Kommentaren und aktuellen News bieten wird darüber hinaus eine Plattform für den aktiven Dialog mit Industrie, Wissenschaft und Verbänden.